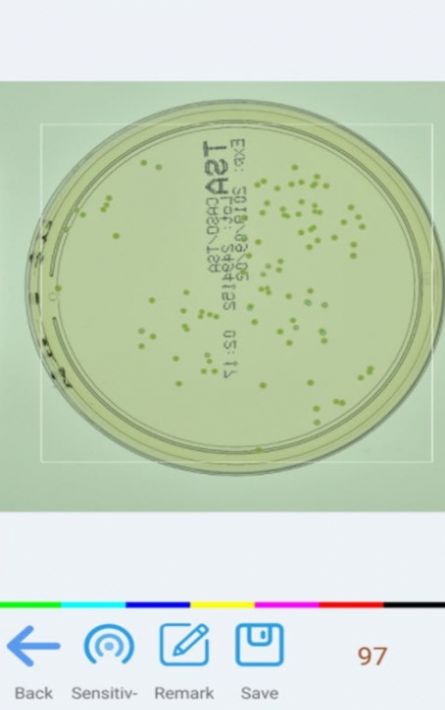
精点相机app

精点相机app这一款特别好用的拍照识别软件,这款软件可以帮助人们识别出图片上的数量多少,而且识别的功能也是比较不错的,精准率特别的高,还能分辨出这些物品的总数,为大家带来更多免费的模板可以使用。

1.平台上提供了非常好用的计数功能,可以通过拍摄的照片去提取数量。
2.还有特别多的常用功能选项,这些功能都是比较靠谱的。
3.不管选择哪项功能去操作,里面的操作步骤都特别的简单。
1.这款平台上还提供了历史记录的功能,帮助用户更好的记录之前所查询的数量。
2.模板库里面的内容也都是特别丰富的,包括工业农业里面的各种数据计算方式。
3.计算的方法也特别的多,大家可以按照上面的提示来操作。
4.界面上提供的内容也都是比较全面的,而且设计的非常工整。

每位用户都可以使用这款软件来计算不同的数量,那么计算出来的结果也是比较靠谱的,计算的时候也是比较快的,不会耽误用户太多的时间,非常适合用于工作中,有需要的用户都可以直接免费注册使用。